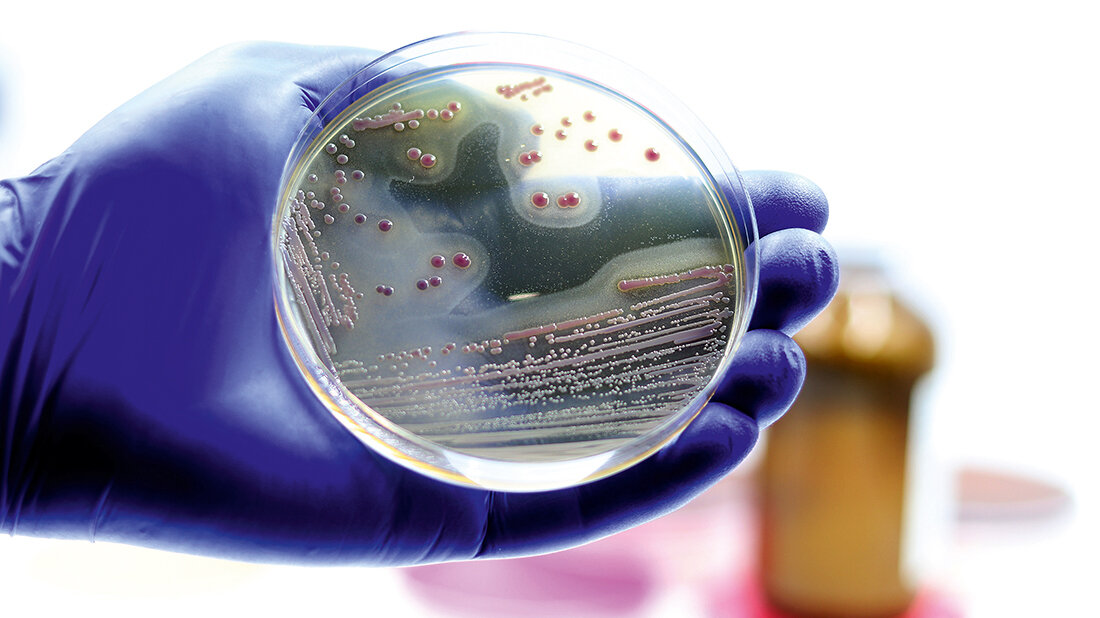
Titelbild des Fachbeitrags über multiresistente Erreger aus der Ukraine
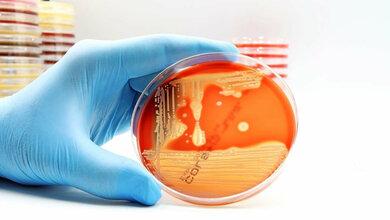
MRSA

Multiresistente Erreger aus der Ukraine
Mehr als 1.000 Personen sind auch direkt aus ukrainischen Krankenhäusern in europäische Kliniken, darunter auch deutsche und niederländische Krankenhäuser, verlegt worden. Zielsetzung derartiger Verlegungen ist eine qualifizierte Weiterbehandlung komplexer Erkrankungen und Verletzungen. Aus der Ukraine selbst berichten öffentliche Krankenhäuser und Militärhospitäler über ein vermehrtes Vorkommen derartiger Erreger im Zeitraum zwischen 2014 (dem Jahr der Besetzung der Krim-Halbinsel) und 2021 [1, 2].
2 aktuelle Berichte aus den Niederlanden und aus Deutschland, die im europäischen Surveillance-Journal „Eurosurveillance“ veröffentlicht wurden, beschreiben jetzt die zu den Fällen ermittelten Hintergrundinformationen und die Ergebnisse der molekularen Analyse der Erregerstämme [3, 4].
Methodik der Erfassung in den Niederlanden
In den Niederlanden besteht seit 2019 eine gesetzliche Meldepflicht für Carbapenem-resistente Enterobakteriazeen. Methicillin-resistente Staphylococcus-aureus-Isolate (MRSA), Carbapenem-resistente Acinetobacter-baumannii-Stämme und Carbapenem-resistente Pseudomonas-aeruginosa-Stämme müssen nicht gemeldet werden. Ihr Auftreten im Krankenhaus soll jedoch durch ein nationales Erfassungssystem gemonitort werden. Zusätzlich beziehungsweise parallel dazu können Isolate zur weiteren Charakterisierung in ein Referenzlabor eingesandt werden. Diese 3 Systeme (Meldepflicht, Erfassung, Einsendung in Referenzlabor) liefern sich größtenteils überlappende, aber auch sich ergänzende Daten. Ein Import der Erreger aus der Ukraine wurde von den niederländischen Autoren angenommen, wenn der betroffene Patient in den 2 Monaten vor Abnahme der Probe in der Ukraine für > 24 Stunden hospitalisiert war [3].
Ergebnisse seit März 2022
Zwischen dem 1. März und 31. August 2022 wurden in den Niederlanden auf diese Weise 47 Carbapenem-resistente Enterobakteriazeen, 12 Carbapenem-resistente Pseudomonas-aeruginosa-Isolate, 3 Carbapenem-resistente Acinetobacter-baumannii-Stämme sowie 13 MRSA-Stämme von 56 Patienten gemeldet beziehungsweise über die Surveillance erfasst. Für 2 zusätzliche, in das Referenzlabor eingesandte, Stämme fand sich keine korrespondierende Meldung oder Surveillance-Erfassung. Insgesamt waren somit 58 Patienten betroffen. Das Kriterium einer Herkunft des Isolates aus der Ukraine erfüllten 39 der betroffenen Personen (67,2 %). Das mittlere Alter der Patienten lag bei 33 Jahren, alle waren männlich. 35 von 39 gramnegativen Stämmen (89 %) und 11 MRSA-Isolate waren in Screening-Abstrichen nachgewiesen worden. 19 gramnegative Erreger und 2 MRSA-Keime stammten aus Wundabstrichen. In 37 Fällen (63,8 %) waren die zur Entdeckung der Keime führenden Abstriche in einem niederländischen Krankenhaus abgenommen worden.
Entnommen aus MT im Dialog 4/2023
Dann nutzen Sie jetzt unser Probe-Abonnement mit 3 Ausgaben zum Kennenlernpreis von € 19,90.
Jetzt Abonnent werden